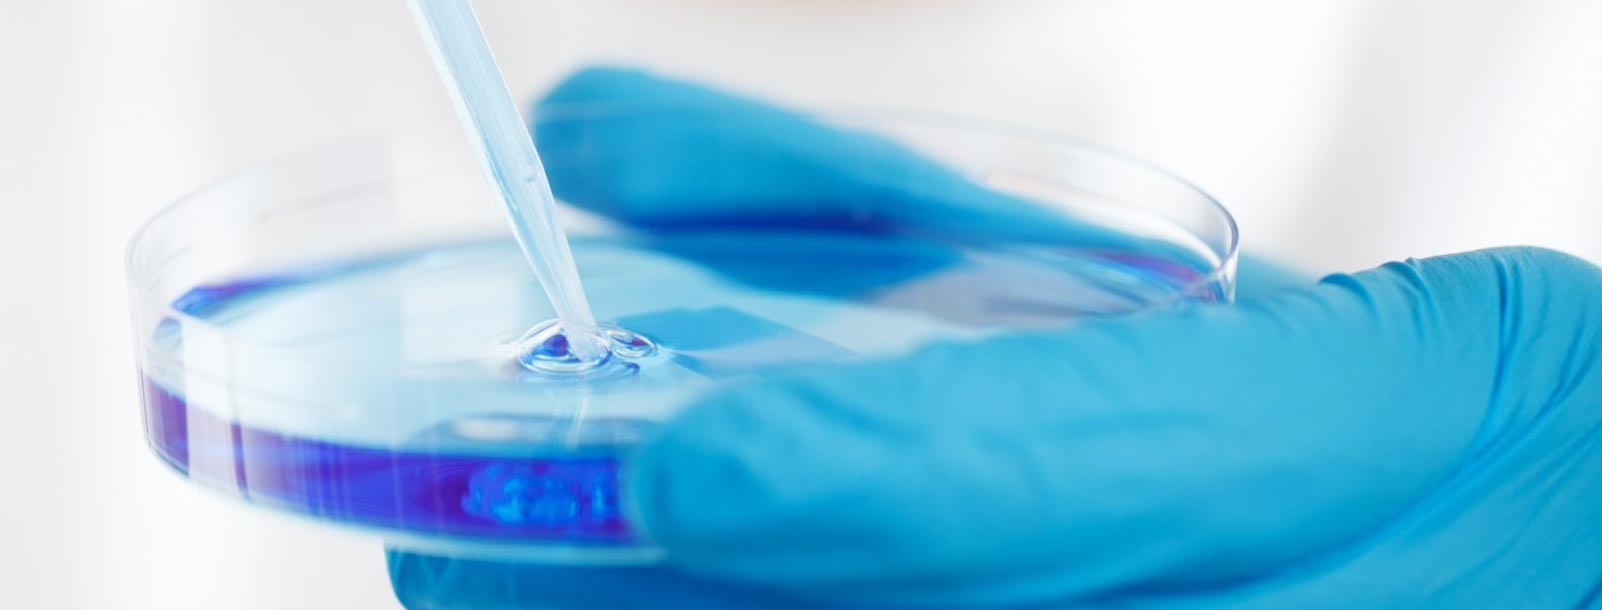

Durchführung interner Veranstaltungen
zur Etablierung onkologisch zertifizierter Praxen
Corporate Design und Identity
Print und Web
Erstellung von Kooperationsverträgen
Erstellung von Finanzplänen
Digitale Spezialisten
Wir sind da um Ihnen beim Wachstum zu helfen
-
10+
Jahre Erfahrung -
85
Glückliche Kunden -
100%
Zufriedenheit
Sicher und Up to date
Wir sind kreativ
Mit kreativen Designs hinterlassen Sie einen guten Eindruck bei Ihren Kunden und Geschäftsfreunden.
Je nach Anforderung an die zu erstellende Webseite integrieren wir für Sie komplexe Datenbanken oder komplette E-Commerce und Content Management (CMS) Lösungen.
Wir sind für Sie das
Lernen Sie unser engagiertes Team kennen

Norbert Schneide
Geschäftsführer
Sandro Leverenz
GeschäftsführerCopyright @ onkomedico by designed4you. All right reserved.